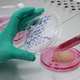

Proizvodnja gojenega mesa danes še ni povsem utečena in razširjena, zato tudi njegova cena še ni konkurenčna. A strokovnjaki s področja celičnega kmetijstva so prepričani, da bo "nova hrana" z … · RTV Slovenija · 7M
rastni serum laboratorijsko gojeno meso genski inženiring bioreaktorji celično kmetijstvo objavi tvitaj

Popolna zamenjava živine z laboratorijskim mesom je še vedno znanstvena fantastika zaradi tehničnih, regulativnih in družbenih omejitev. Velika Britanija je prva evropska država, ki je dovolila prodajo laboratorijskega mesa za … · Finance · 1L

Ameriški regulatorji so v sredo prvič v zgodovini dovolili prodajo perutnine oz. piščančjega mesa, ki je bilo pridelano v laboratoriju iz živalskih celic. Dve kalifornijski podjetji sta od ministrstva za … · Delo in dom · 2L

Sliši se predobro, da bi bilo res – meso brez nasičenih maščob, brez rastnih hormonov, antibiotikov, mikroplastike. Ne le piščanec in govedina, kmalu bodo na trgovske police prišle tudi umetno … · Metropolitan.si · 3L
sonaravna pridelava ribe zdrava prehrana laboratorijsko meso objavi tvitaj

Sistem oskrbe s hrano se bo v prihodnosti spremenil. Kakšen bo naš jedilnik? Oskrba s hrano postaja vse pomembnejša družbena tema. Pridelava hrane je močno odvisna od podnebnih pogojev, obenem … · Žurnal24 · 4L

Vegetarijanci že dolgo poznajo razne nadomestke za meso, ki se proizvajajo iz rastlinskih virov beljakovin. Če ste mesojed, pa verjamem, da se boste zelo težko odrekli pravemu zrezku. Kaj pa, … · 24ur · 4L
laboratorijsko pridelano blog meso boban pauković objavi tvitaj
Nič več zakola. Prodajali bodo meso, vzgojeno v laboratoriju. Singapur je postal prva država v svetu, ki je odobrila prodajo loaboratorijsko vzgojenega mesa. V sredo je državna agencija za hrano … · Svet24 · 5L
laboratorijsko meso rastlinsko prehranjevanje meso objavi tvitaj